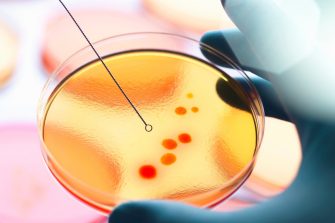
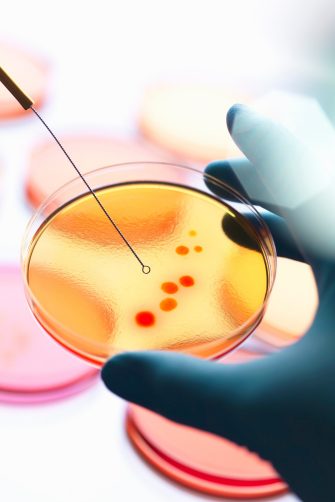

New data on antibiotic resistance patterns in UTIs could help guide future treatment decisions.
Urinary tract infections (UTIs) caused by E. coli from aged care facilities show higher resistance to antibiotics compared to cases collected from hospitals and the wider community, find researchers from UNSW Sydney.
New research, recently published in the journal Open Forum Infectious Diseases, also found that antibiotic resistance in UTIs reduced over the course of the COVID-19 pandemic.
In Australia there have been recent reports of increasing local rates of antibiotic resistance. Associate Professor Li Zhang from UNSW’s School of Biological and Biomedical Sciences (BABS), who led the study, wanted to see how antibiotic resistance was impacting UTI treatment.
Results from this latest study provide valuable insights for medical professionals in effectively managing UTIs and for the relevant Australian authorities in formulating antibiotic treatment approaches of UTIs.
“We believe this is a really important element to be considered in the treatment of those who are affected by UTIs,” says A/Prof. Zhang.
Media enquiries
For enquiries about this story and to arrange interviews please contact Lilly Matson.
Tel: 0426656007
Email: l.matson@unsw.edu.au
What is a UTI?
UTIs are highly prevalent infections, with an estimated global incidence of over 400 million cases per year.
“A UTI is an infection in the urinary tract, which can be caused by a number of different bacterial types, known collectively as uropathogens,” says Ms Alex Young, a UNSW PhD candidate and co-author on the study. “The typical symptoms are frequency and urgency to urinate and pain when urinating. In a severe situation, the bacteria can travel up from the urinary tract and into the kidney, where it may transfer into blood and cause sepsis, which is very serious.”
In Australia, UTIs account for approximately 1.5 per cent of all GP consultations, equating to roughly 2.62 million GP visits a year. The standard treatment for this type of infection is an antibiotic known as trimethoprim.
“Infections are really common, but are particularly frequent in women and older people,” says Ms Young. In fact, nearly one in three women will have had at least one episode of UTI that requires antimicrobial therapy before they are 24 years old.
And like any infection that requires antibiotics, there is a risk of antibiotic resistance.
Antibiotic resistance in UTIs
Antimicrobial resistance is considered one of the most important threats to modern medicine by the World Health Organisation. In the case of UTIs, antibiotic resistance is associated with delayed symptom resolution, which can increase the chance of kidney infections.
“In each country, there are various recommended antibiotics for treating UTIs,” says A/Prof. Zhang. “Recommendations are usually based on the local antibiotic resistant pattern. And for this reason, it’s important that antibiotic resistant patterns are continuously measured and analysed.”
Recommendations on UTI management are regularly updated by various health authorities and scientific societies, and in turn, this can influence policy. For example, recent changes to UTI treatments have been made in France and the UK in response to managing changing antibiotic resistance.
Ms Young, A/Prof. Zhang and their collaborators analysed the pathogen composition and corresponding antibiotic resistance of 775,559 UTI samples from across New South Wales. These samples were collected from communities via GPs, hospitals, and aged care facilities before and during the COVID-19 pandemic.
Changing resistance patterns
Once the team had access to these samples, which was made possible through the partnership with Douglass Hanly Moir Pathology, it was time to find out more about the specific types of uropathogen causing the UTI and how likely they were to respond to treatment.
“We first examined how the bacterial species composition varied across clinical settings,” says Ms Young.
“We also looked at how antibiotic resistance rates were different depending on the setting that the sample had come from.
“Then with all this information, we did further statistical tests and mathematical modeling to predict the likelihood of resistance to currently recommended antibiotics for treating UTIs, in any given setting.”
These tests found that the overall resistance of uropathogens to trimethoprim, the standard course of antibiotics given in Australia to treat UTIs, was high. The most common type of uropathogen, E.coli, had a resistance rate of 20–30 per cent, depending on the clinical setting.
“Generally, a resistance rate higher than 20 per cent would be cause for concern,” says A/Prof. Zhang. “Societies in Europe and America have identified a 20 per cent resistance rate as the cutoff for effective trimethoprim therapy.”
In the United Kingdom and the Netherlands, similarly high trimethoprim resistance was addressed by changing the suggested therapy to an alternative antibiotic.
“E. coli resistance to trimethoprim was highest when you look at infections within the aged care setting, followed by hospitals, then the community,” says Ms Young. “We also identified, particularly in aged care facilities, that there was a reduction in resistance from about 2020, and saw a decreasing trend in resistance into 2022.”
The team hypothesised that this downward pattern may have been a result of increased infection control during the pandemic.
“In hospitals and aged care, there's a much higher chance of being able to catch a very resistant infection from that environment because there's a lot more resistant bacteria around as well as people who are generally unwell and less likely to be able to fight an infection,” says Ms Young.
A call to clinicians and policymakers
This latest study has provided useful insight into the treatment landscape of UTIs in Australia.
"This data may be a worthwhile tool to help clinicians and policymakers evaluate whether trimethoprim is still the most appropriate antibiotic for the first line treatment of UTIs,” says Ms Young. “While there are many factors to consider when making treatment recommendations, antibiotic resistance is definitely a key element.
“As well as affecting older people, the burden of UTIs also falls heavily on women. UTIs can have a huge impact of people's health and quality of life, so it's important that challenges like antibiotic resistance are addressed."
Next, the team want to identify exactly where the different pathogens have come from, and why E. coli bacteria in aged care facilities tend to have the highest rate of resistance to trimethoprim.
“Is it because older people in aged care facilities have visited hospitals and acquired the resistant UTI there? Or is it because antibiotic resistant strains are circulating in the aged care facility itself?” says A/Prof. Zhang. “The more we know, the better we can devise strategies to control or reduce this antibiotic resistance.”